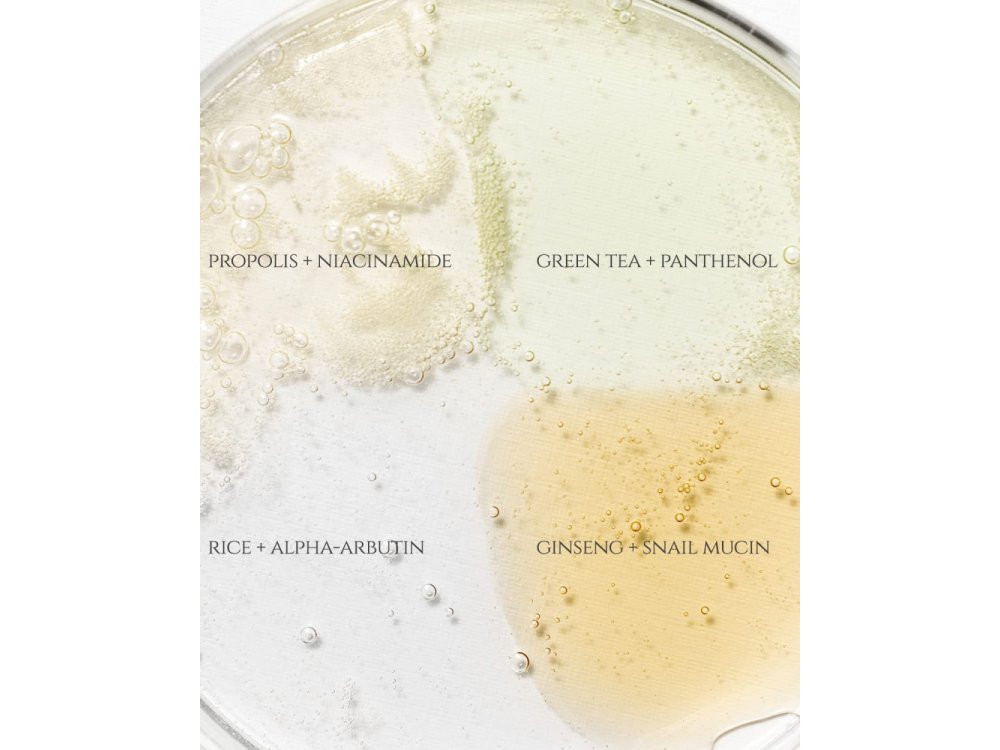

Beauty of Joseon Hanbang Serum Discovery Kit, Συλλογή 4 Ενυδατικών ορών, 4x10ml
Το Hanbang Serum Discovery Kit της Beauty of Joseon είναι ένα όμορφο set που περιλαμβάνει τα 4 αγαπημένα serums της Κορεατικης εταιρίας σε μινι συσκευασίες των 10ml.
Αποτελεί μια ιδανική λύση για όσους θέλουν να δοκιμάσουν όλους τους ορούς πριν καταλήξουν σε αυτόν ή αυτούς που ταιριάζουν καλύτερα στην επιδερμίδα τους. Επιπλέον είναι τέλεια επιλογή γιατί οι ανάγκες της επιδερμίδας μας δεν είναι πάντα οι ίδιες. Σίγουρα θα έχουν υπάρξει μέρες που νιώθετε το δέρμα σας ιδιαίτερα λιπαρό ή αφυδατωμένο ή ξηρό ή θαμπό. Το σετ αυτό είναι η τέλεια επιλογή για να εφαρμόζετε στην επιδερμίδα σας αυτό που πραγματικά ζητά.
Calming serum: Πράσινο Τσάι + Πανθενόλη (10 ml)
Βασικά συστατικά: Νερό από φύλλα πράσινου τσαγιού 76% + Πανθενόλη 2%
Συστατικά που ξεχωρίσαμε: Εκχύλισμα Centella Asiatica, εκχύλισμα Artemisia Vulgaris, Υαλουρονικό νάτριο
Υφή: Ελαφριά λεπτόρρευστη υφή
Οφέλη: Διαθέτει καταπραϋντικές και ηρεμιστικές ιδιότητες.
Glow serum: Πρόπολη + Νιασιναμίδη (10 ml)
Βασικά συστατικά : Εκχύλισμα πρόπολης 60% + νιασιναμίδη 2%
Συστατικά που ξεχωρίσαμε: σαλικυλική βεταΐνη (BHA), έλαιο Tamanu, εκχύλισμα τεϊόδεντρου
Υφή: Υφή σαν μέλι
Οφέλη: Διαθέτει αντιφλεγμονώδεις ιδιότητες και είναι ιδανικό για άτομα με τάση ακμής.
Glow Deep Serum: Ρύζι + άλφα-αρβουτίνη (10ml)
Βασικά συστατικά: Νερό από πίτουρο ρυζιού 68% + άλφα-αρβουτίνη 2%
Συστατικά που ξεχωρίσαμε: Γλυκερίνη, νιασιναμίδι, εκχύλισμα σπόρων σόγιας, εκχύλισμα κριθαριού, εκχύλισμα ρυζιού, εκχύλισμα σουσαμιού
Υφή: Ελαφριά λεπτόρρευστη υφή
Οφέλη: Προσφέρει λάμψη και καταπολέμα την υπερμελάγχρωση.
Revive Serum: Ginseng + βλεννίνη σαλιγκαριού (10ml)
Βασικά συστατικά: Εκχύλισμα ρίζας Ginseng 63% + Snail Mucin 3%
Συστατικά που ξεχωρίσαμε: Εκχύλισμα ρίζας Ginseng, Αδενοσίνη, Εκχύλισμα Matsutake
Υφή: Ελαφριά υφή που μοιάζει με βλεννίνη
Οφέλη: Διαθέτει αντιρυτιδικές ιδιότητες και βοηθά στην υπερμελάγχρωση.
H Beauty of Joseon είναι μια cruelty free εταιρία που βασίζει την παραγωγγή των προιόντων της στην παραδοσιακή Κορεατικη ιατρική.
Κατάλληλα για όλους τους τύπους δέρματος.
Βάρος: 0.50 kg
Περιγραφή
Το Hanbang Serum Discovery Kit της Beauty of Joseon είναι ένα όμορφο set που περιλαμβάνει τα 4 αγαπημένα serums της Κορεατικης εταιρίας σε μινι συσκευασίες των 10ml.
Αποτελεί μια ιδανική λύση για όσους θέλουν να δοκιμάσουν όλους τους ορούς πριν καταλήξουν σε αυτόν ή αυτούς που ταιριάζουν καλύτερα στην επιδερμίδα τους. Επιπλέον είναι τέλεια επιλογή γιατί οι ανάγκες της επιδερμίδας μας δεν είναι πάντα οι ίδιες. Σίγουρα θα έχουν υπάρξει μέρες που νιώθετε το δέρμα σας ιδιαίτερα λιπαρό ή αφυδατωμένο ή ξηρό ή θαμπό. Το σετ αυτό είναι η τέλεια επιλογή για να εφαρμόζετε στην επιδερμίδα σας αυτό που πραγματικά ζητά.
Calming serum: Πράσινο Τσάι + Πανθενόλη (10 ml)
Βασικά συστατικά: Νερό από φύλλα πράσινου τσαγιού 76% + Πανθενόλη 2%
Συστατικά που ξεχωρίσαμε: Εκχύλισμα Centella Asiatica, εκχύλισμα Artemisia Vulgaris, Υαλουρονικό νάτριο
Υφή: Ελαφριά λεπτόρρευστη υφή
Οφέλη: Διαθέτει καταπραϋντικές και ηρεμιστικές ιδιότητες.
Glow serum: Πρόπολη + Νιασιναμίδη (10 ml)
Βασικά συστατικά : Εκχύλισμα πρόπολης 60% + νιασιναμίδη 2%
Συστατικά που ξεχωρίσαμε: σαλικυλική βεταΐνη (BHA), έλαιο Tamanu, εκχύλισμα τεϊόδεντρου
Υφή: Υφή σαν μέλι
Οφέλη: Διαθέτει αντιφλεγμονώδεις ιδιότητες και είναι ιδανικό για άτομα με τάση ακμής.
Glow Deep Serum: Ρύζι + άλφα-αρβουτίνη (10ml)
Βασικά συστατικά: Νερό από πίτουρο ρυζιού 68% + άλφα-αρβουτίνη 2%
Συστατικά που ξεχωρίσαμε: Γλυκερίνη, νιασιναμίδι, εκχύλισμα σπόρων σόγιας, εκχύλισμα κριθαριού, εκχύλισμα ρυζιού, εκχύλισμα σουσαμιού
Υφή: Ελαφριά λεπτόρρευστη υφή
Οφέλη: Προσφέρει λάμψη και καταπολέμα την υπερμελάγχρωση.
Revive Serum: Ginseng + βλεννίνη σαλιγκαριού (10ml)
Βασικά συστατικά: Εκχύλισμα ρίζας Ginseng 63% + Snail Mucin 3%
Συστατικά που ξεχωρίσαμε: Εκχύλισμα ρίζας Ginseng, Αδενοσίνη, Εκχύλισμα Matsutake
Υφή: Ελαφριά υφή που μοιάζει με βλεννίνη
Οφέλη: Διαθέτει αντιρυτιδικές ιδιότητες και βοηθά στην υπερμελάγχρωση.
H Beauty of Joseon είναι μια cruelty free εταιρία που βασίζει την παραγωγγή των προιόντων της στην παραδοσιακή Κορεατικη ιατρική.
Κατάλληλα για όλους τους τύπους δέρματος.

-1.png)



-1.png)

